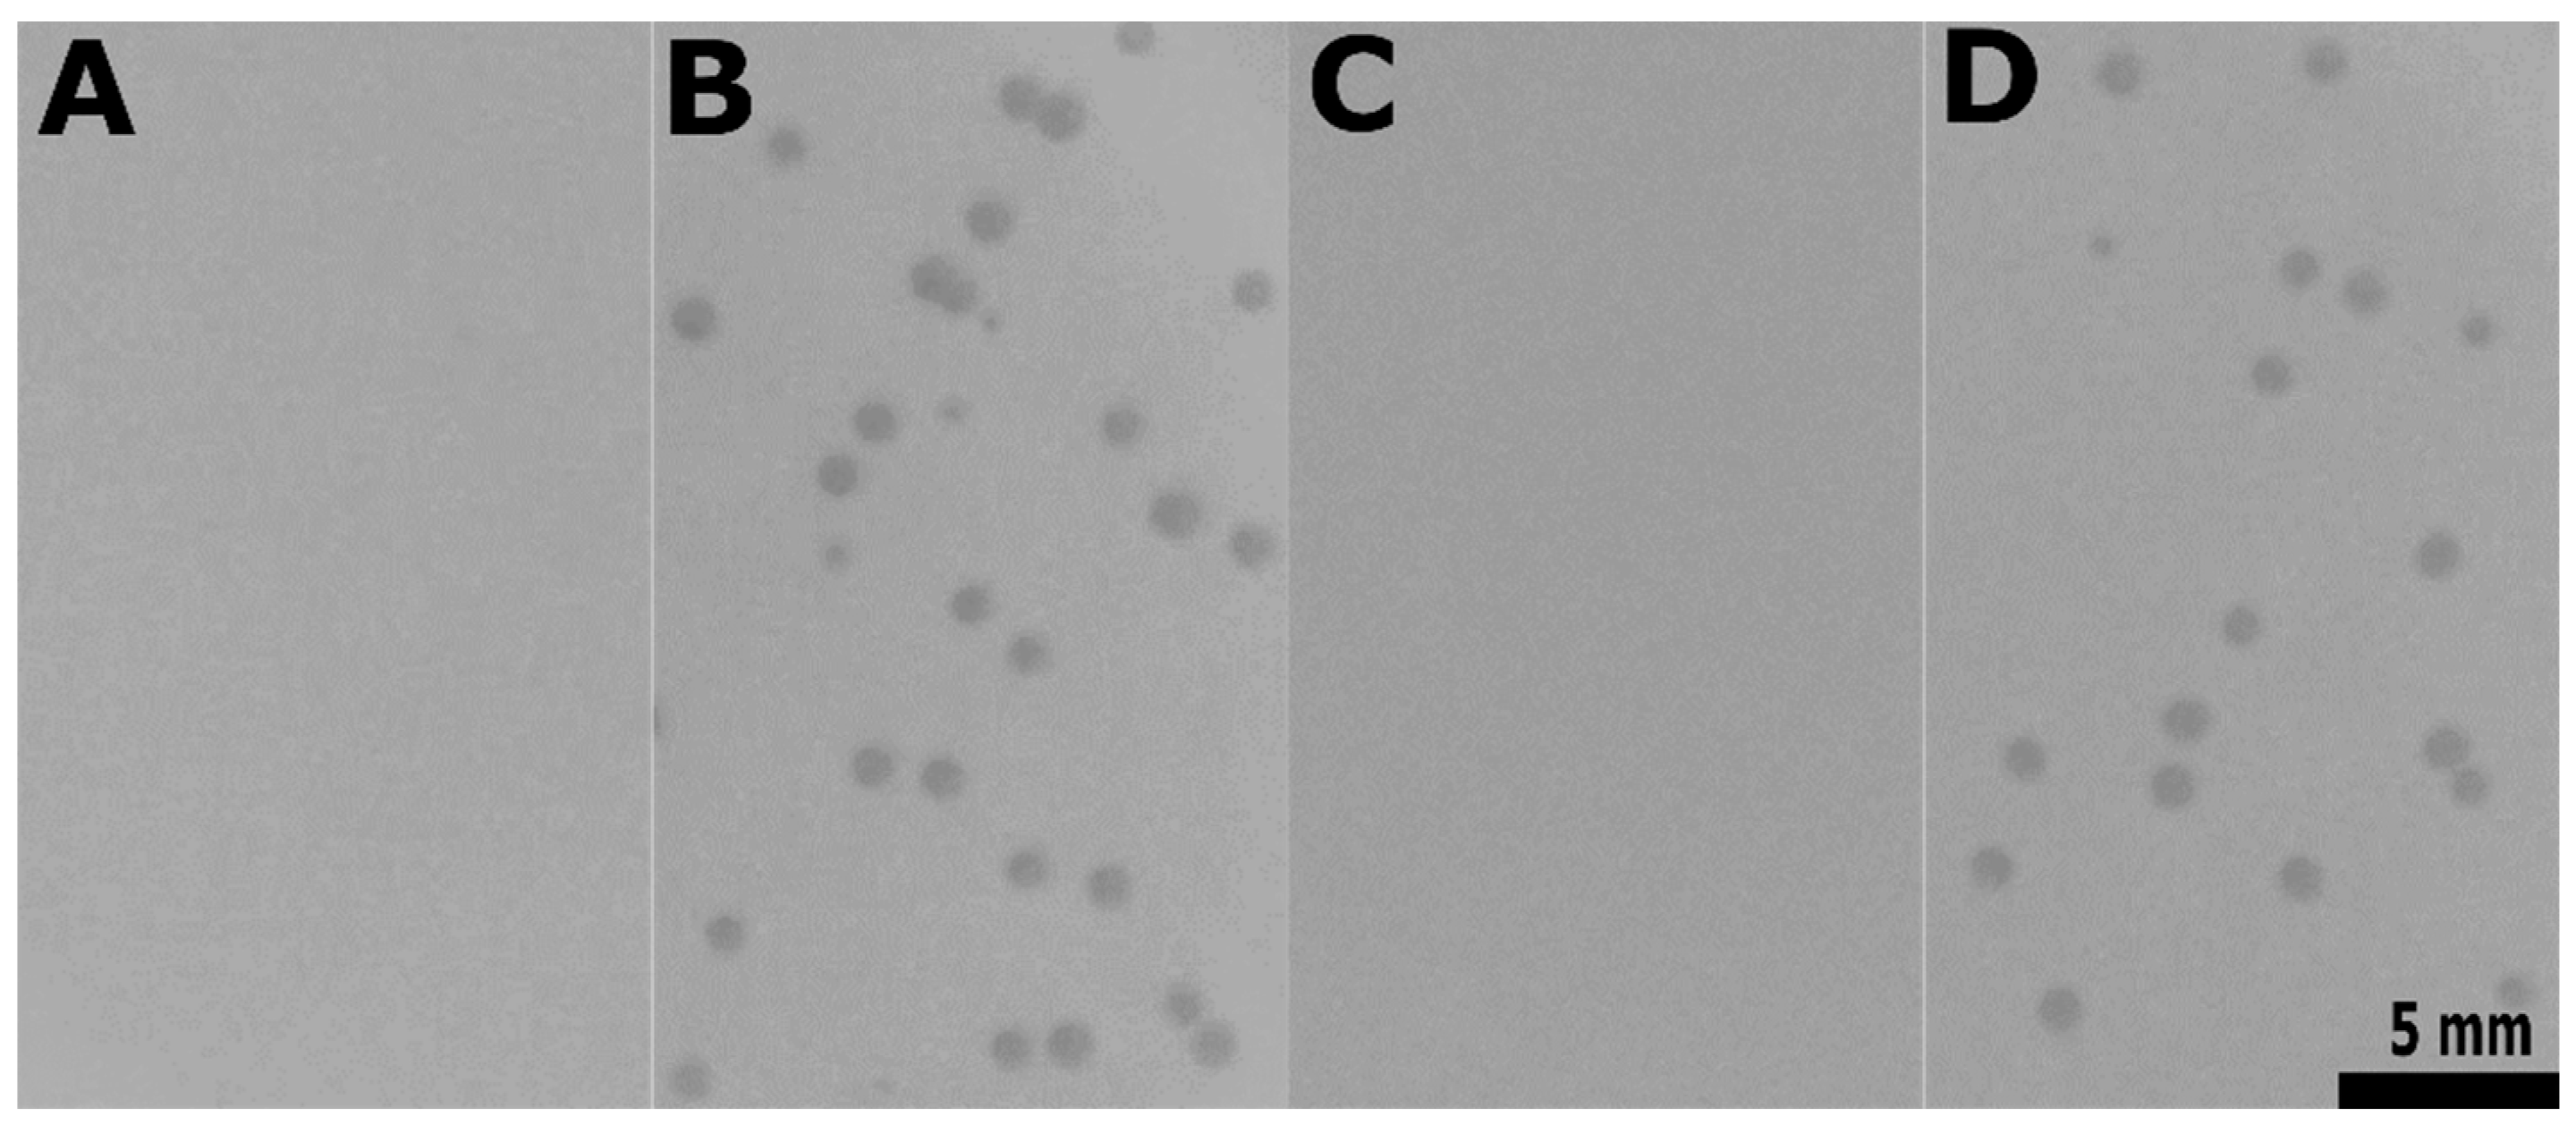
Viruses 11 00048 g007 Viruses 11 00048 g007

Enterococcus faecalis Countermeasures Defeat a Virulent Picovirinae Bacteriophage
Abstract
1. Introduction
2. Materials and Methods
2.1. Sample for Bacteriophage Isolation, Bacterial Strains, Plasmids, and Growth Conditions
2.2. Phage Isolation
2.3. Phage Concentration and Purification
2.4. Phage Examination in Transmission Electron Microscopy
2.5. Phage Genomic Nucleic Acid Extraction, Whole Genome Sequencing, and Bioinformatic Analysis
2.6. Determination of Phage Burst Size
2.7. Determination of Phage Host Range
2.8. Determination of Phage Efficiency of Plaquing
2.9. Phage Adsorption Assay
2.10. Determination of Phage Efficiency of Center of Infection
2.11. Bacterial Survival Assay
2.12. Lysis Curve Experiments
2.13. Luria–Delbrück Fluctuation Tests
2.14. General Molecular Biology Methods
2.15. Cloning of IDF_13 and IDF_15, Expression and Preparation of Extracts of E. coli, and Spot Assay of the Extracts on the Indicator Strain
2.16. Construction of E. faecalis VE18306 ef2833-, ef2847- and ef2850-Complemented Strains and E. faecalis VE18590 ef2833- Complemented Strain
2.17. PCR Amplification in epaX Region
2.18. Construction of E. faecalis VE18306∆epaX Strain
2.19. Construction of E. faecalis VE18393 epaX—Complemented Strain
3. Results
3.1. Characterization of the Enterococcus Phage Idefix
3.1.1. Isolation, Morphological Characterization, and Phage–Host Relationship
3.1.2. Genomic Characterization
3.1.3. Phage Host Range
3.2. Characterization of E. faecalis V583 Resistance to Idefix
3.2.1. Novel Abi System Encoded by V583 Prophage 6
3.2.2. Mutagenesis in V583 epa Variable Region as Potential Additional Line of Defense
4. Discussion
5. Conclusions
Supplementary Materials
Author Contributions
Acknowledgments
Conflicts of Interest
References
- Lebreton, F.; Willems, R.J.; Gilmore, M.S. Enterococcus diversity, origins in nature, and gut colonization. In Enterococci from Commensals to Leading Causes of Drug Resistant Infection; Gilmore, M.S., Clewell, D.B., Ike, Y., Shankar, N., Eds.; Massachusetts Eye and Ear Infirmary: Boston, MA, USA, 2014; pp. 3–46. [Google Scholar]
- Higuita, N.I.A.; Huycke, M.M. Enterococcal disease, epidemiology, and implications for treatment. In Enterococci from Commensals to Leading Causes of Drug Resistant Infection; Gilmore, M.S., Clewell, D.B., Ike, Y., Shankar, N., Eds.; Massachusetts Eye and Ear Infirmary: Boston, MA, USA, 2014; pp. 47–72. [Google Scholar]
- Kristich, C.J.; Rice, L.B.; Arias, C.A. Enterococcal infection—Treatment and antibiotic resistance. In Enterococci from Commensals to Leading Causes of Drug Resistant Infection; Gilmore, M.S., Clewell, D.B., Ike, Y., Shankar, N., Eds.; Massachusetts Eye and Ear Infirmary: Boston, MA, USA, 2014; pp. 89–134. [Google Scholar]
- Sulakvelidze, A.; Alavidze, Z.; Morris, J.G. Bacteriophage therapy. Antimicrob. Agents Chemother. 2001, 45, 649–659. [Google Scholar] [CrossRef] [PubMed]
- Cheng, M.; Liang, J.; Zhang, Y.; Hu, L.; Gong, P.; Cai, R.; Zhang, L.; Zhang, H.; Ge, J.; Ji, Y.; et al. The bacteriophage EF-P29 efficiently protects against lethal vancomycin-resistant Enterococcus faecalis and alleviates gut microbiota imbalance in a murine bacteremia model. Front. Microbiol. 2017, 8, 837. [Google Scholar] [CrossRef]
- Cheng, S.; Xing, S.; Zhang, X.; Pei, G.; An, X.; Mi, Z.; Huang, Y.; Tong, Y. Complete genome sequence of a new Enterococcus faecalis bacteriophage, vB_EfaS_IME197. Genome Announc. 2016, 4, e00827-16. [Google Scholar] [CrossRef] [PubMed]
- Duerkop, B.A.; Palmer, K.L.; Horsburgh, M.J. Enterococcal bacteriophages and genome defense. In Enterococci from Commensals to Leading Causes of Drug Resistant Infection; Gilmore, M.S., Clewell, D.B., Ike, Y., Shankar, N., Eds.; Massachusetts Eye and Ear Infirmary: Boston, MA, USA, 2014; pp. 309–336. [Google Scholar]
- Gelman, D.; Beyth, S.; Lerer, V.; Adler, K.; Poradosu-Cohen, R.; Coppenhagen-Glazer, S.; Hazan, R. Combined bacteriophages and antibiotics as an efficient therapy against VRE Enterococcus faecalis in a mouse model. Res. Microbiol. 2018, 169, 531–539. [Google Scholar] [CrossRef]
- Gong, P.; Cheng, M.; Li, X.; Jiang, H.; Yu, C.; Kahaer, N.; Li, J.; Zhang, L.; Xia, F.; Hu, L.; et al. Characterization of Enterococcus faecium bacteriophage IME-EFm5 and its endolysin LysEFm5. Virology 2016, 492, 11–20. [Google Scholar] [CrossRef]
- Khalifa, L.; Brosh, Y.; Gelman, D.; Coppenhagen-Glazer, S.; Beyth, S.; Poraduso-Cohen, R.; Que, Y.-A.; Beyth, N.; Hazan, R. Targeting Enterococcus faecalis biofilm using phage therapy. Appl. Environ. Microbiol. 2015, 81, 2696–2705. [Google Scholar] [CrossRef] [PubMed]
- Khalifa, L.; Gelman, D.; Shlezinger, M.; Dessal, A.L.; Coppenhagen-Glazer, S.; Beyth, N.; Hazan, R. Defeating antibiotic-and phage-resistant Enterococcus faecalis using a phage cocktail in vitro and in a clot model. Front. Microbiol. 2018, 9, 326. [Google Scholar] [CrossRef]
- Rahmat Ullah, S.; Andleeb, S.; Raza, T.; Jamal, M.; Mehmood, K. Effectiveness of a lytic Phage SRG1 against vancomycin-resistant Enterococcus faecalis in compost and soil. Biomed. Res. Int. 2017, 2017. [Google Scholar] [CrossRef]
- Wang, R.; Xing, S.; Zhao, F.; Li, P.; Mi, Z.; Shi, T.; Liu, H.; Tong, Y. Characterization and genome analysis of novel phage vB_EfaP_IME195 infecting Enterococcus faecalis. Virus Genes 2018, 54, 804–811. [Google Scholar] [CrossRef]
- Xing, S.; Zhang, X.; Sun, Q.; Wang, J.; Mi, Z.; Pei, G.; Huang, Y.; An, X.; Fu, K.; Zhou, L.; et al. Complete genome sequence of a novel, virulent Ahjdlikevirus bacteriophage that infects Enterococcus faecium. Arch.Virol. 2017, 162, 3843–3847. [Google Scholar] [CrossRef]
- Zhang, W.; Mi, Z.; Yin, X.; Fan, H.; An, X.; Zhang, Z.; Chen, J.; Tong, Y. Characterization of Enterococcus faecalis phage IME-EF1 and its endolysin. PLoS ONE 2013, 8, e80435. [Google Scholar] [CrossRef] [PubMed]
- Duerkop, B.A.; Huo, W.; Bhardwaj, P.; Palmer, K.L.; Hooper, L.V. molecular basis for lytic bacteriophage resistance in enterococci. MBio. 2016, 7. [Google Scholar] [CrossRef] [PubMed]
- Labrie, S.J.; Samson, J.E.; Moineau, S. Bacteriophage resistance mechanisms. Nat. Rev. Microbiol. 2010, 8, 317–327. [Google Scholar] [CrossRef] [PubMed]
- Seed, K.D. Battling Phages: How bacteria defend against viral attack. PLoS Pathog. 2015, 11, e1004847. [Google Scholar] [CrossRef] [PubMed]
- Goldfarb, T.; Sberro, H.; Weinstock, E.; Cohen, O.; Doron, S.; Charpak-Amikam, Y.; Afik, S.; Ofir, G.; Sorek, R. BREX is a novel phage resistance system widespread in microbial genomes. EMBO J. 2014, 34, 169–183. [Google Scholar] [CrossRef]
- Doron, S.; Melamed, S.; Ofir, G.; Leavitt, A.; Lopatina, A.; Keren, M.; Amitai, G.; Sorek, R. Systematic discovery of antiphage defense systems in the microbial pangenome. Science 2018, 359, eaar4120. [Google Scholar] [CrossRef]
- Depardieu, F.; Didier, J.-P.; Bernheim, A.; Sherlock, A.; Molina, H.; Duclos, B.; Bikard, D. A eukaryotic-like serine/threonine kinase protects staphylococci against phages. Cell Host Microbe 2016, 20, 471–481. [Google Scholar] [CrossRef]
- Ofir, G.; Melamed, S.; Sberro, H.; Mukamel, Z.; Silverman, S.; Yaakov, G.; Doron, S.; Sorek, R. DISARM is a widespread bacterial defence system with broad anti-phage activities. Nat. Microbiol. 2018, 3, 90–98. [Google Scholar] [CrossRef]
- Kronheim, S.; Daniel-Ivad, M.; Duan, Z.; Hwang, S.; Wong, A.I.; Mantel, I.; Nodwell, J.R.; Maxwell, K.L. A chemical defence against phage infection. Nature 2018, 564, 283–286. [Google Scholar] [CrossRef]
- Burley, K.M.; Sedgley, C.M. CRISPR-Cas, a prokaryotic adaptive immune system, in endodontic, oral, and multidrug-resistant hospital-acquired Enterococcus faecalis. J. Endod. 2012, 38, 1511–1515. [Google Scholar] [CrossRef]
- Hullahalli, K.; Rodrigues, M.; Schmidt, B.D.; Li, X.; Bhardwaj, P.; Palmer, K.L. Comparative analysis of the orphan CRISPR2 locus in 242 Enterococcus faecalis strains. PLoS ONE 2015, 10, e0138890. [Google Scholar] [CrossRef] [PubMed]
- Lindenstrauß, A.G.; Pavlovic, M.; Bringmann, A.; Behr, J.; Ehrmann, M.A.; Vogel, R.F. Comparison of genotypic and phenotypic cluster analyses of virulence determinants and possible role of CRISPR elements towards their incidence in Enterococcus faecalis and Enterococcus faecium. Syst. Appl. Microbiol. 2011, 34, 553–560. [Google Scholar] [CrossRef] [PubMed]
- Price, V.J.; Huo, W.; Sharifi, A.; Palmer, K.L. CRISPR-cas and restriction-modification act additively against conjugative antibiotic resistance plasmid transfer in Enterococcus faecalis. mSphere 2016, 1. [Google Scholar] [CrossRef] [PubMed]
- Huo, W.; Adams, H.M.; Zhang, M.Q.; Palmer, K.L. Genome modification in Enterococcus faecalis OG1RF assessed by bisulfite sequencing and single-molecule real-time sequencing. J. Bacteriol. 2015, 197, 1939–1951. [Google Scholar] [CrossRef] [PubMed]
- Palmer, K.L.; Gilmore, M.S. Multidrug-resistant enterococci lack CRISPR-cas. MBio 2010, 1, e00227-10. [Google Scholar] [CrossRef] [PubMed]
- Hullahalli, K.; Rodrigues, M.; Nguyen, U.T.; Palmer, K. An attenuated CRISPR-cas system in Enterococcus faecalis permits DNA acquisition. MBio 2018, 9, e00414-18. [Google Scholar] [CrossRef]
- Villarreal, L.P. Viral ancestors of antiviral systems. Viruses 2011, 3, 1933–1958. [Google Scholar] [CrossRef]
- Arber, W.; Dussoix, D. Host specificity of DNA produced by Escherichia coli. I. Host controlled modification of bacteriophage lambda. J. Mol. Biol. 1962, 5, 18–36. [Google Scholar] [CrossRef]
- Seed, K.D.; Lazinski, D.W.; Calderwood, S.B.; Camilli, A. A bacteriophage encodes its own CRISPR/cas adaptive response to evade host innate immunity. Nature 2013, 494, 489–491. [Google Scholar] [CrossRef]
- Nilsson, A.S.; Karlsson, J.L.; Haggård-Ljungquist, E. Site-specific recombination links the evolution of P2-like coliphages and pathogenic enterobacteria. Mol. Biol. Evol. 2004, 21, 1–13. [Google Scholar] [CrossRef]
- Kintz, E.; Davies, M.R.; Hammarlöf, D.L.; Canals, R.; Hinton, J.C.D.; van der Woude, M.W. A BTP1 prophage gene present in invasive non-typhoidal Salmonella determines composition and length of the O-antigen of the lipopolysaccharide. Mol. Microbiol. 2015, 96, 263–275. [Google Scholar] [CrossRef] [PubMed]
- Cumby, N.; Edwards, A.M.; Davidson, A.R.; Maxwell, K.L. The bacteriophage HK97 gp15 moron element encodes a novel superinfection exclusion protein. J. Bacteriol. 2012, 194, 5012–5019. [Google Scholar] [CrossRef] [PubMed]
- Mahony, J.; McGrath, S.; Fitzgerald, G.F.; van Sinderen, D. Identification and characterization of lactococcal-prophage-carried superinfection exclusion genes. Appl. Environ. Microbiol. 2008, 74, 6206–6215. [Google Scholar] [CrossRef] [PubMed]
- Bebeacua, C.; Lorenzo Fajardo, J.C.; Blangy, S.; Spinelli, S.; Bollmann, S.; Neve, H.; Cambillau, C.; Heller, K.J. X-ray structure of a superinfection exclusion lipoprotein from phage TP-J34 and identification of the tape measure protein as its target. Mol. Microbiol. 2013, 89, 152–165. [Google Scholar] [CrossRef] [PubMed]
- Bondy-Denomy, J.; Qian, J.; Westra, E.R.; Buckling, A.; Guttman, D.S.; Davidson, A.R.; Maxwell, K.L. Prophages mediate defense against phage infection through diverse mechanisms. ISME J 2016, 10, 2854–2866. [Google Scholar] [CrossRef] [PubMed]
- Dedrick, R.M.; Jacobs-Sera, D.; Bustamante, C.A.G.; Garlena, R.A.; Mavrich, T.N.; Pope, W.H.; Reyes, J.C.C.; Russell, D.A.; Adair, T.; Alvey, R.; et al. Prophage-mediated defence against viral attack and viral counter-defence. Nat. Microbiol. 2017, 2, 16251. [Google Scholar] [CrossRef] [PubMed]
- Parma, D.H.; Snyder, M.; Sobolevski, S.; Nawroz, M.; Brody, E.; Gold, L. The Rex system of bacteriophage lambda: Tolerance and altruistic cell death. Genes Dev. 1992, 6, 497–510. [Google Scholar] [CrossRef] [PubMed]
- Friedman, D.I.; Mozola, C.C.; Beeri, K.; Ko, C.-C.; Reynolds, J.L. Activation of a prophage-encoded tyrosine kinase by a heterologous infecting phage results in a self-inflicted abortive infection. Mol. Microbiol. 2011, 82, 567–577. [Google Scholar] [CrossRef]
- Matos, R.C.; Lapaque, N.; Rigottier-Gois, L.; Debarbieux, L.; Meylheuc, T.; Gonzalez-Zorn, B.; Repoila, F.; de Lopes, M.F.; Serror, P. Enterococcus faecalis prophage dynamics and contributions to pathogenic traits. PLoS Genet. 2013, 9, e1003539. [Google Scholar] [CrossRef]
- Jurczak-Kurek, A.; Gąsior, T.; Nejman-Faleńczyk, B.; Bloch, S.; Dydecka, A.; Topka, G.; Necel, A.; Jakubowska-Deredas, M.; Narajczyk, M.; Richert, M.; et al. Biodiversity of bacteriophages: Morphological and biological properties of a large group of phages isolated from urban sewage. Sci. Rep 2016, 6, 34338. [Google Scholar] [CrossRef]
- Dumoulin, R.; Cortes-Perez, N.; Gaubert, S.; Duhutrel, P.; Brinster, S.; Torelli, R.; Sanguinetti, M.; Posteraro, B.; Repoila, F.; Serror, P. Enterococcal Rgg-like regulator ElrR activates expression of the elrA operon. J. Bacteriol. 2013, 195, 3073–3083. [Google Scholar] [CrossRef]
- Gasson, M.J. Plasmid complements of Streptococcus lactis NCDO 712 and other lactic streptococci after protoplast-induced curing. J. Bacteriol. 1983, 154, 1–9. [Google Scholar] [PubMed]
- Renault, P.; Corthier, G.; Goupil, N.; Delorme, C.; Ehrlich, S.D. Plasmid vectors for gram-positive bacteria switching from high to low copy number. Gene 1996, 183, 175–182. [Google Scholar] [CrossRef]
- Rigottier-Gois, L.; Alberti, A.; Houel, A.; Taly, J.-F.; Palcy, P.; Manson, J.; Pinto, D.; Matos, R.C.; Carrilero, L.; Montero, N.; et al. Large-scale screening of a targeted Enterococcus faecalis mutant library identifies envelope fitness factors. PLoS ONE 2011, 6, e29023. [Google Scholar] [CrossRef]
- Rigottier-Gois, L.; Madec, C.; Navickas, A.; Matos, R.C.; Akary-Lepage, E.; Mistou, M.-Y.; Serror, P. The surface rhamnopolysaccharide Epa of Enterococcus faecalis is a key determinant of intestinal colonization. J. Infect. Dis. 2015, 211, 62–71. [Google Scholar] [CrossRef]
- Sahm, D.F.; Marsilio, M.K.; Piazza, G. Antimicrobial resistance in key bloodstream bacterial isolates: Electronic surveillance with the Surveillance Network Database-USA. Clin. Infect. Dis. 1999, 29, 259–263. [Google Scholar] [CrossRef] [PubMed]
- Fritzenwanker, M.; Kuenne, C.; Billion, A.; Hain, T.; Zimmermann, K.; Goesmann, A.; Chakraborty, T.; Domann, E. Complete Genome Sequence of the Probiotic Enterococcus faecalis Symbioflor 1 Clone DSM 16431. Genome Announc. 2013, 1, e00165-12. [Google Scholar] [CrossRef] [PubMed]
- Jamet, E.; Akary, E.; Poisson, M.-A.; Chamba, J.-F.; Bertrand, X.; Serror, P. Prevalence and characterization of antibiotic resistant Enterococcus faecalis in French cheeses. Food. Microbiol. 2012, 31, 191–198. [Google Scholar] [CrossRef]
- Fortier, L.-C.; Moineau, S. Phage production and maintenance of stocks, including expected stock lifetimes. Methods Mol. Biol. 2009, 501, 203–219. [Google Scholar] [PubMed]
- Pickard, D.J.J. Preparation of bacteriophage lysates and pure DNA. Methods Mol. Biol. 2009, 502, 3–9. [Google Scholar]
- Summer, E.J. Preparation of a phage DNA fragment library for whole genome shotgun sequencing. Methods Mol. Biol. 2009, 502, 27–46. [Google Scholar] [PubMed]
- Margulies, M.; Egholm, M.; Altman, W.E.; Attiya, S.; Bader, J.S.; Bemben, L.A.; Berka, J.; Braverman, M.S.; Chen, Y.-J.; Chen, Z.; et al. Genome sequencing in microfabricated high-density picolitre reactors. Nature 2005, 437, 376–380. [Google Scholar] [CrossRef] [PubMed]
- Aziz, R.K.; Bartels, D.; Best, A.A.; DeJongh, M.; Disz, T.; Edwards, R.A.; Formsma, K.; Gerdes, S.; Glass, E.M.; Kubal, M.; et al. The RAST Server: Rapid annotations using subsystems technology. BMC Genom. 2008, 9, 75. [Google Scholar] [CrossRef] [PubMed]
- Sullivan, M.J.; Petty, N.K.; Beatson, S.A. Easyfig: A genome comparison visualizer. Bioinformatics 2011, 27, 1009–1010. [Google Scholar] [CrossRef]
- Hyman, P.; Abedon, S.T. Practical methods for determining phage growth parameters. Methods Mol. Biol. 2009, 501, 175–202. [Google Scholar]
- Garvey, P.; Hill, C.; Fitzgerald, G.F. The lactococcal plasmid pNP40 encodes a third bacteriophage resistance mechanism, one which affects phage DNA penetration. Appl. Environ. Microbiol. 1996, 62, 676–679. [Google Scholar]
- Sing, W.D.; Klahenhammer, T.R. Characteristics of phage abortion conferred in lactococci by the congugal plasmid pTR2030. J. Mol. Biol. 1990, 136, 1807–1815. [Google Scholar]
- Behnke, D.; Malke, H. Bacteriophage interference in Streptococcus pyogenes. II. A25 mutants resistant to prophage-medicated interference. Virology 1978, 85, 129–136. [Google Scholar] [CrossRef]
- Luria, S.E.; Delbrück, M. Mutations of bacteria from virus sensitivity to virus resistance. Genetics 1943, 28, 491–511. [Google Scholar]
- Dower, W.J.; Miller, J.F.; Ragsdale, C.W. High efficiency transformation of E. coli by high voltage electroporation. Nucleic Acids Res. 1988, 16, 6127–6145. [Google Scholar] [CrossRef]
- Dunny, G.M.; Lee, L.N.; LeBlanc, D.J. Improved electroporation and cloning vector system for gram-positive bacteria. Appl. Environ. Microbiol. 1991, 57, 1194–1201. [Google Scholar] [PubMed]
- Brinster, S.; Furlan, S.; Serror, P. C-terminal WxL domain mediates cell wall binding in Enterococcus faecalis and other gram-positive bacteria. J. Bacteriol. 2007, 189, 1244–1253. [Google Scholar] [CrossRef] [PubMed]
- Blanco, L.; Salas, M. Relating structure to function in phi29 DNA polymerase. J. Biol. Chem. 1996, 271, 8509–8512. [Google Scholar] [CrossRef] [PubMed]
- Dufour, E.; Méndez, J.; Lázaro, J.M.; de Vega, M.; Blanco, L.; Salas, M. An aspartic acid residue in TPR-1, a specific region of protein-priming DNA polymerases, is required for the functional interaction with primer terminal protein1. J. Mol. Biol. 2000, 304, 289–300. [Google Scholar] [CrossRef] [PubMed]
- Eisenbrandt, R.; Lázaro, J.M.; Salas, M.; Vega, M. de. Phi29 DNA polymerase residues Tyr59, His61 and Phe69 of the highly conserved ExoII motif are essential for interaction with the terminal protein. Nucleic Acids Res. 2002, 30, 1379–1386. [Google Scholar] [CrossRef]
- Meijer, W.J.J.; Horcajadas, J.A.; Salas, M. φ29 Family of Phages. Microbiol. Mol. Biol. Rev. 2001, 65, 261–287. [Google Scholar] [CrossRef]
- Rodríguez, I.; Lázaro, J.M.; Blanco, L.; Kamtekar, S.; Berman, A.J.; Wang, J.; Steitz, T.A.; Salas, M.; de Vega, M. A specific subdomain in phi29 DNA polymerase confers both processivity and strand-displacement capacity. Proc. Natl. Acad. Sci. USA 2005, 102, 6407–6412. [Google Scholar] [CrossRef]
- Redrejo-Rodríguez, M.; Salas, M. Multiple roles of genome-attached bacteriophage terminal proteins. Virology 2014, 468–470, 322–329. [Google Scholar] [CrossRef]
- Redrejo-Rodríguez, M.; Muñoz-Espín, D.; Holguera, I.; Mencía, M.; Salas, M. Nuclear and nucleoid localization are independently conserved functions in bacteriophage terminal proteins. Mol. Microbiol. 2013, 90, 858–868. [Google Scholar] [CrossRef] [PubMed][Green Version]
- Bateman, A.; Rawlings, N.D. The CHAP domain: A large family of amidases including GSP amidase and peptidoglycan hydrolases. Trends Biochem. Sci. 2003, 28, 234–237. [Google Scholar] [CrossRef]
- McGowan, S.; Buckle, A.M.; Mitchell, M.S.; Hoopes, J.T.; Gallagher, D.T.; Heselpoth, R.D.; Shen, Y.; Reboul, C.F.; Law, R.H.P.; Fischetti, V.A.; et al. X-ray crystal structure of the streptococcal specific phage lysin PlyC. Proc. Natl. Acad. Sci. USA 2012, 109, 12752–12757. [Google Scholar] [CrossRef] [PubMed]
- Rigden, D.J.; Jedrzejas, M.J.; Galperin, M.Y. Amidase domains from bacterial and phage autolysins define a family of gamma-D,L-glutamate-specific amidohydrolases. Trends Biochem. Sci. 2003, 28, 230–234. [Google Scholar] [CrossRef]
- Nelson, D.; Schuch, R.; Chahales, P.; Zhu, S.; Fischetti, V.A. PlyC: A multimeric bacteriophage lysin. Proc. Natl. Acad. Sci. USA 2006, 103, 10765–10770. [Google Scholar] [CrossRef] [PubMed]
- Lavigne, R.; Seto, D.; Mahadevan, P.; Ackermann, H.-W.; Kropinski, A.M. Unifying classical and molecular taxonomic classification: Analysis of the Podoviridae using BLASTP-based tools. Res. Microbiol. 2008, 159, 406–414. [Google Scholar] [CrossRef] [PubMed]
- McGrath, S.; Fitzgerald, G.F.; van Sinderen, D. Identification and characterization of phage-resistance genes in temperate lactococcal bacteriophages. Mol. Microbiol. 2002, 43, 509–520. [Google Scholar] [CrossRef] [PubMed]
- Innocenti, N.; Golumbeanu, M.; d’ Hérouël, A.F.; Lacoux, C.; Bonnin, R.A.; Kennedy, S.P.; Wessner, F.; Serror, P.; Bouloc, P.; Repoila, F.; et al. Whole-genome mapping of 5′ RNA ends in bacteria by tagged sequencing: A comprehensive view in Enterococcus faecalis. Rna 2015, 21, 1018–1031. [Google Scholar] [CrossRef] [PubMed]
- Chopin, M.-C.; Chopin, A.; Bidnenko, E. Phage abortive infection in lactococci: Variations on a theme. Curr. Opin. Microbiol. 2005, 8, 473–479. [Google Scholar] [CrossRef]
- Paez-Espino, D.; Roux, S.; Chen, I.-M.A.; Palaniappan, K.; Ratner, A.; Chu, K.; Huntemann, M.; Reddy, T.B.K.; Pons, J.C.; Llabrés, M.; et al. IMG/VR v.2.0: An integrated data management and analysis system for cultivated and environmental viral genomes. Nucleic Acids Res. 2018. [Google Scholar] [CrossRef]
- Nelson, D.; Schuch, R.; Zhu, S.; Tscherne, D.M.; Fischetti, V.A. Genomic sequence of C1, the first streptococcal phage. J. Bacteriol. 2003, 185, 3325–3332. [Google Scholar] [CrossRef]
- Palmer, K.L.; Godfrey, P.; Griggs, A.; Kos, V.N.; Zucker, J.; Desjardins, C.; Cerqueira, G.; Gevers, D.; Walker, S.; Wortman, J.; et al. Comparative genomics of enterococci: Variation in Enterococcus faecalis, clade structure in E. faecium, and defining characteristics of E. gallinarum and E. casseliflavus. MBio 2012, 3, e00318-11. [Google Scholar] [CrossRef]
- Nelson, D.C.; Schmelcher, M.; Rodriguez-Rubio, L.; Klumpp, J.; Pritchard, D.G.; Dong, S.; Donovan, D.M. Endolysins as antimicrobials. Adv. Virus Res. 2012, 83, 299–365. [Google Scholar] [PubMed]
- Cheng, M.; Zhang, Y.; Li, X.; Liang, J.; Hu, L.; Gong, P.; Zhang, L.; Cai, R.; Zhang, H.; Ge, J.; et al. Endolysin LysEF-P10 shows potential as an alternative treatment strategy for multidrug-resistant Enterococcus faecalis infections. Sci. Rep. 2017, 7, 10164. [Google Scholar] [CrossRef] [PubMed]
- Chowdhury, R.; Biswas, S.K.; Das, J. Abortive replication of choleraphage phi 149 in Vibrio cholerae biotype el tor. J. Virol. 1989, 63, 392–397. [Google Scholar] [PubMed]
- Rettenmier, C.W.; Hemphill, H.E. Abortive infection of lysogenic Bacillus subtilis 168(SPO2) by bacteriophage phi 1. J. Virol. 1974, 13, 870–880. [Google Scholar] [PubMed]
- Smith, H.S.; Pizer, L.I.; Pylkas, L.; Lederberg, S. Abortive infection of Shigella dysenteriae P2 by T2 bacteriophage. J. Virol. 1969, 4, 162–168. [Google Scholar] [PubMed]
- Tran, L.S.; Szabó, L.; Ponyi, T.; Orosz, L.; Sík, T.; Holczinger, A. Phage abortive infection of Bacillus licheniformis ATCC 9800; identification of the abiBL11 gene and localisation and sequencing of its promoter region. Appl. Microbiol. Biotechnol. 1999, 52, 845–852. [Google Scholar] [CrossRef] [PubMed]
- Snyder, L. Phage-exclusion enzymes: A bonanza of biochemical and cell biology reagents? Mol. Microbiol. 1995, 15, 415–420. [Google Scholar] [CrossRef]
- Stern, A.; Sorek, R. The phage-host arms race: Shaping the evolution of microbes. Bioessays 2011, 33, 43–51. [Google Scholar] [CrossRef]
- Durmaz, E.; Klaenhammer, T.R. Abortive phage resistance mechanism AbiZ speeds the lysis clock to cause premature lysis of phage-infected Lactococcus lactis. J. Bacteriol. 2007, 189, 1417–1425. [Google Scholar] [CrossRef]
- Young, R. Phage lysis: Three steps, three choices, one outcome. J. Microbiol. 2014, 52, 243–258. [Google Scholar] [CrossRef]
- Wang, I.N.; Smith, D.L.; Young, R. Holins: The protein clocks of bacteriophage infections. Annu. Rev. Microbiol. 2000, 54, 799–825. [Google Scholar] [CrossRef] [PubMed]
- Ho, K.; Huo, W.; Pas, S.; Dao, R.; Palmer, K.L. Loss-of-Function Mutations in epaR Confer Resistance to ϕNPV1 Infection in Enterococcus faecalis OG1RF. Antimicrob. Agents Chemother. 2018, 62. [Google Scholar] [CrossRef] [PubMed]
- Teng, F.; Singh, K.V.; Bourgogne, A.; Zeng, J.; Murray, B.E. Further characterization of the epa gene cluster and Epa polysaccharides of Enterococcus faecalis. Infect. Immun. 2009, 77, 3759–3767. [Google Scholar] [CrossRef] [PubMed]
- Chapot-Chartier, M.-P. Interactions of the cell-wall glycopolymers of lactic acid bacteria with their bacteriophages. Front. Microbiol. 2014, 5, 236. [Google Scholar] [CrossRef] [PubMed]
- Mistou, M.-Y.; Sutcliffe, I.C.; van Sorge, N.M. Bacterial glycobiology: Rhamnose-containing cell wall polysaccharides in Gram-positive bacteria. FEMS Microbiol. Rev. 2016, 40, 464–479. [Google Scholar] [CrossRef]
- Ainsworth, S.; Sadovskaya, I.; Vinogradov, E.; Courtin, P.; Guerardel, Y.; Mahony, J.; Grard, T.; Cambillau, C.; Chapot-Chartier, M.-P.; van Sinderen, D. Differences in lactococcal cell wall polysaccharide structure are major determining factors in bacteriophage sensitivity. MBio 2014, 5, e00880-14. [Google Scholar] [CrossRef]

| Strain (Genotype) | Average EOP of Idefix (sd) | Plaque (Diameter) |
|---|---|---|
| VE18590 (pp−) | 1 | Big clear plaque (3–4 mm) |
| VE18562 (pp1+) | 1.1 (0.17) | Big clear plaque (3–4 mm) |
| VE18582 (pp4+) | 0.92 (0.14) | Big clear plaque (3–4 mm) |
| VE18589 (pp7+) | 1.03 (0.16) | Big clear plaque (3–4 mm) |
| VE18583 (pp3+, pp5+) | 0.97 (0.16) | Reduction in size (1 mm) |
| VE18584 (pp3+) | 0.92 (0.17) | Reduction in size (1 mm) |
| VE18581 (pp6+) | 0 * | No plaque visible |
| VE18306 (pp6−) | 1 (0.13) | Reduction in size (1 mm) |
| Strain (Genotype) | % EOP (Plaques Diameter) | % Adsorption (sd) | % ECOI (sd) | % Bacterial Death at MOI 1 (sd) and MOI 10 (sd) |
|---|---|---|---|---|
| Indicator strain VE18590 (pp−) | 100 (3–4 mm) | 96.5 (1.63) | 100 | 69.0 (0.39) and 99.2 (0.78) |
| VE18306 (pp6−) | 100 (1 mm) | 97.1 (1.35) | 69.3 (3.10) | 52.8 (3.00) and 98.2 (0.98) |
| VE18581 (pp6+) | 0 None plaques visible | 97.5 (0.92) | 39.5 (3.94) | 66.8 (2.78) and 98.2 (1.32) |
| VE14089 (pp+) | 0 None plaques visible | 98.1 (2.36) | 15.9 (4.01) | 60.2 (3.46) and 98.9 (0.19) |
| VEJL3 (pp6−, ef2833+) | 0 None plaques visible | 98.4 (0.68) | 9.46 (2.68) | 67.7 (1.65) and 98.6 (0.46) |
| VEJL5 (pp−, ef2833+) | 0 None plaques visible | 98.5 (1.33) | 13.8 (0.58) | 63.2 (1.98) and 96.6 (1.36) |
© 2019 by the authors. Licensee MDPI, Basel, Switzerland. This article is an open access article distributed under the terms and conditions of the Creative Commons Attribution (CC BY) license (http://creativecommons.org/licenses/by/4.0/).
Share and Cite
Lossouarn, J.; Briet, A.; Moncaut, E.; Furlan, S.; Bouteau, A.; Son, O.; Leroy, M.; DuBow, M.S.; Lecointe, F.; Serror, P.; et al. Enterococcus faecalis Countermeasures Defeat a Virulent Picovirinae Bacteriophage. Viruses 2019, 11, 48. https://doi.org/10.3390/v11010048
Lossouarn J, Briet A, Moncaut E, Furlan S, Bouteau A, Son O, Leroy M, DuBow MS, Lecointe F, Serror P, et al. Enterococcus faecalis Countermeasures Defeat a Virulent Picovirinae Bacteriophage. Viruses. 2019; 11(1):48. https://doi.org/10.3390/v11010048
Chicago/Turabian StyleLossouarn, Julien, Arnaud Briet, Elisabeth Moncaut, Sylviane Furlan, Astrid Bouteau, Olivier Son, Magali Leroy, Michael S. DuBow, François Lecointe, Pascale Serror, and et al. 2019. "Enterococcus faecalis Countermeasures Defeat a Virulent Picovirinae Bacteriophage" Viruses 11, no. 1: 48. https://doi.org/10.3390/v11010048
APA StyleLossouarn, J., Briet, A., Moncaut, E., Furlan, S., Bouteau, A., Son, O., Leroy, M., DuBow, M. S., Lecointe, F., Serror, P., & Petit, M.-A. (2019). Enterococcus faecalis Countermeasures Defeat a Virulent Picovirinae Bacteriophage. Viruses, 11(1), 48. https://doi.org/10.3390/v11010048

